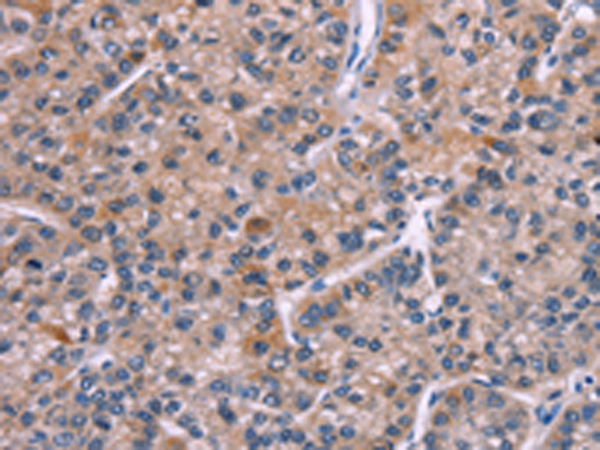
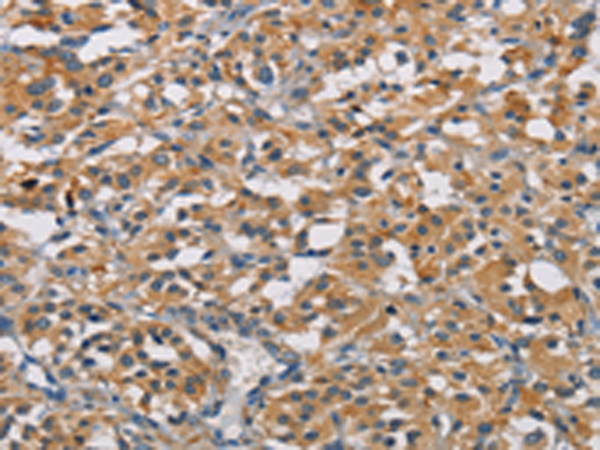
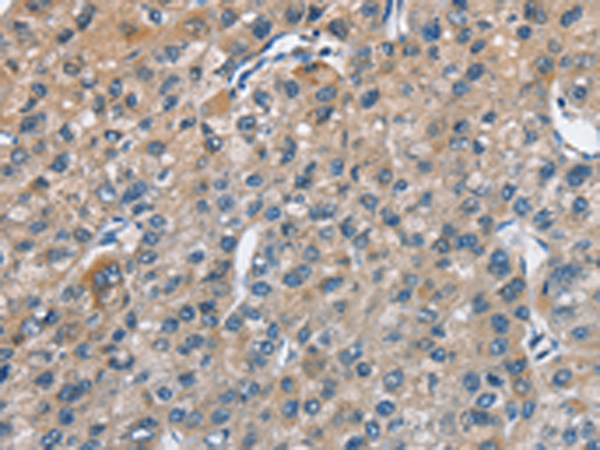

-
分类: 科研抗体货号: P08018别名: MSS4; STM7应用: IHC反应种属: Human, Mouse, Rat
-
分类: 科研抗体货号: P07998别名: M6A; GPM6应用: WB,IHC反应种属: Human, Mouse, Rat
-
分类: 科研抗体货号: P08016别名: CBR; hCBR1; SDR21C1应用: WB,IHC反应种属: Human, Mouse, Rat
-
分类: 科研抗体货号: P07997别名: DFNB98; TSP-EAR; C21orf29应用: IHC反应种属: Human
-
分类: 科研抗体货号: P08015别名: HCKIE; CKIepsilon应用: IHC反应种属: Human, Mouse
-
分类: 科研抗体货号: P07996别名: CBY; arb1; PGEA1; C22orf2; Chibby1; PIGEA14; PIGEA-14; HS508I15A应用: IHC反应种属: Human, Mouse, Rat
-
分类: 科研抗体货号: P08014别名: PGKA; MIG10应用: WB,IHC反应种属: Human, Mouse, Rat
-
分类: 科研抗体货号: P07995别名:应用: IHC反应种属: Human
-
分类: 科研抗体货号: P08012别名:应用: WB,IHC反应种属: Human, Mouse, Rat
-
分类: 科研抗体货号: P08030别名: ASC1; ASC-1; HsT17391应用: WB,IHC反应种属: Human, Mouse

鄂公网安备42018502007531号
鄂公网安备42018502007531号

